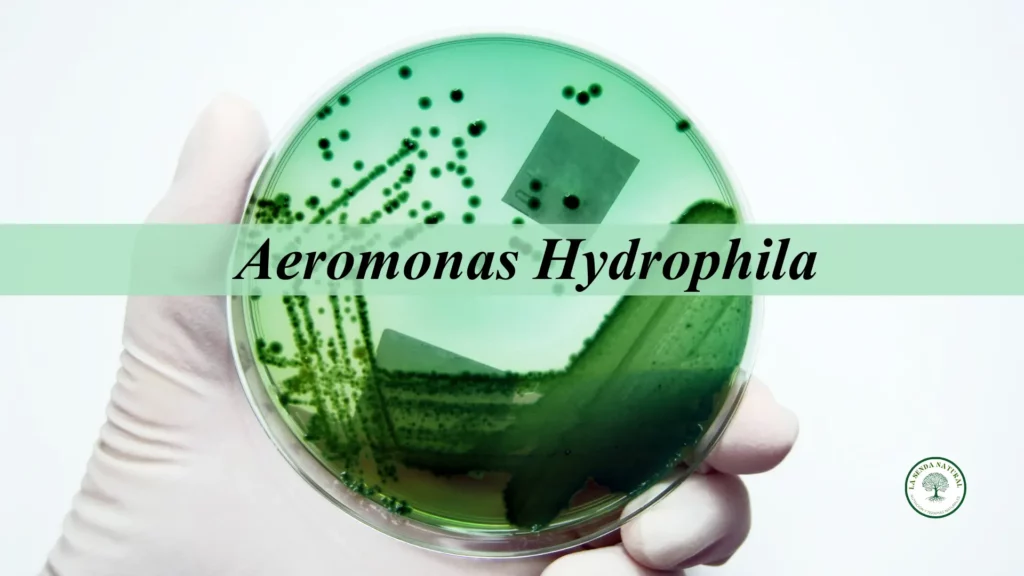
Aeromonas Hydropila

Técnicas de Conservación por Frío
REFRIGERACIÓN

Técnicas de conservación por Frío. Estas técnicas de conservación de los alimentos se basan en enfriar y mantener los alimentos a temperaturas próximas a los 0ºC (las temperaturas más adecuadas según el tipo de alimento, así como la colocación de los alimentos para evitar la contaminación cruzada).
- Frigorífico industrial: 2-5º C
- Frigorífico doméstico: 4-8ºC
A parte del mantenimiento constante de las temperaturas de refrigeración (con variación máxima de 1-2ºC), es importante controlar la humedad, que en general es alta, del 80-90% (si la humedad es menor se produce desecación en la superficie de los alimentos).
La refrigeración modifica poco las características sensoriales (se pierden aromas) y el valor nutritivo de los alimentos (lo más significativo es la pérdida de vit C) pero el período de conservación que proporciona al alimento es relativamente corto.
La refrigeración no impide el desarrollo de microorganismos, o reacciones químicas como la oxidación lipídica o los pardeamientos, simplemente los enlentece. Los microorganismos patógenos en general no crecen a menos de 5ºC.
La vida útil de los alimentos sometidos a refrigeración es muy variable, ya que depende de muchos factores.
En el caso de los productos frescos, depende de la fragilidad del alimento, de las condiciones específicas del alimento en el momento de la recolección, sacrificio o captura, de la temperatura de almacenamiento y distribución previas, de la humedad ambiental, etc.
En el caso de los alimentos procesados, depende del tipo de producto, del grado de inactivación de los microorganismos y enzimas durante de procesado, del control de la higiene durante el procesado y envasado, del tipo de envase y de la temperatura de almacenamiento.
Conservación por Frío: CONGELACIÓN

La congelación consiste en someter al alimento a temperaturas inferiores a la temperatura de congelación de los fluidos celulares. La temperatura a la que se congelan los alimentos es igual o inferior a –18ºC (habitualmente –20 o –22ºC). La congelación proporciona dos efectos:
- disminuye la temperatura
- disminuye la aW
Ambas detienen prácticamente por completo las reacciones químicas y bioquímicas que producen las alteraciones. La aw disminuye ya que en la congelación el agua del alimento pasa de líquido a sólido (hielo).
La velocidad de la mayoría de reacciones químicas y enzimáticas disminuyen, tanto por no disponer de agua líquida como por el efecto de las bajas temperaturas.
La congelación permite la conservación durante períodos prolongados de tiempo, con cambios mínimos en las características nutricionales y organolépticas.
El proceso de congelación debe realizarse de forma rápida para evitar la ruptura de las membranas celulares. Al congelar un alimento, el agua que contiene el alimento forma cristales de hielo, la formación de cristales de hielo se produce en dos etapas:
- Nucleación: se forman los núcleos del futuro cristal de hielo.
- Crecimiento: los núcleos crecen hasta formar los cristales.
Si la velocidad de nucleación es superior a la velocidad de crecimiento de los cristales, se formarán un gran número de núcleos que crecerán poco, por lo que los cristales de agua serán pequeños y redondeados y no desgarrarán las membranas celulares, este tipo de cristales son propios de la ultra congelación y proporciona una óptima conservación del alimento.
Si la velocidad de crecimiento es superior a la velocidad de nucleación, se forman pocos núcleos que crecen hasta convertirse en cristales de hielo grandes y puntiagudos, que rompen las membranas celulares, de manera que se pierde el agua intracelular, esto tendrá consecuencias al descongelar el producto, ya que no se recupera la textura original, estos cristales de hielo son propios de la congelación tradicional
Si la congelación es rápida, al descongelar se recupera la textura original del alimento.
Requisitos del producto para una buena congelación:
_ El producto debe ser fresco y de buena calidad.
_ El producto, dependiendo de su naturaleza, debe tener un procesado previo adecuado
_ El envasado del producto debe ser adecuado
La ultra congelación es un procedimiento que congela lo más rápidamente posible (máximo en 2 horas) el alimento a muy baja temperatura (-40ºC). Una vez ultracongelado, el alimento se conserva en cámaras de congelación (-18 a –22ºC).
Con este método se obtienen productos de mejor calidad, ya que se congela todo el alimento a la vez, no se rompen células ni tejidos.

En la congelación tradicional, la temperatura deseada (-18 a –22ºC), se consigue más lentamente (3-72 horas), se forman pocos núcleos de cristalización, que dan lugar a grandes cristales que rompen las estructuras, este fenómeno pone en contacto a los enzimas con sus sustratos, acelerándose las reacciones enzimáticas.
**Sólo deben congelarse / ultra congelarse alimentos que se encuentren en perfecto estado.
Durante el almacenamiento del alimento congelado se pueden perder aromas, textura, color y puede haber pérdidas de algunas vitaminas, sobre todo las hidrosolubles, especialmente la vitamina C.
Antes del congelado, sobre todo en alimentos vegetales, éstos se suelen someter a un proceso de escaldado, de forma que se inactivan los enzimas responsables de los pardeamientos enzimáticos, así como microorganismos, pero al mismo tiempo este proceso conlleva una pérdida de vitamina C del 15 al 20%.
A pesar de esta pérdida, si las verduras y frutas se congelan en condiciones inmejorables (poco después de ser cosechadas) generalmente presentan mejores cualidades nutritivas que sus equivalentes «frescas».
En ocasiones, los productos cosechados tardan días en ser seleccionados, transportados y distribuidos a los comercios. Durante este tiempo, los alimentos pueden perder vitaminas progresivamente.
Las bayas y las verduras verdes pueden perder hasta un 15% de su contenido de vitamina C al día si se almacenan a temperatura ambiente.
Conservación por Frío: Procedimientos de congelación
- Congelación por aire frío, con o sin corriente de aire
Es un método rápido y económico. Si se hace con corriente de aire y el alimento no está convenientemente envasado se produce desecación superficial - Congelación por contacto indirecto con un refrigerante.
En este tipo de congelación se coloca el producto que se va a congelar sobre placas metálicas por las cuales circula un refrigerante.
La transferencia de calor es por conducción, y la eficiencia de la congelación depende de la superficie de contacto entre la placa y el alimento.

- Congelación por contacto directo con un refrigerante.
También se denomina método de congelación por inmersión y consiste en sumergir el alimento que se desea congelar en fluidos a temperatura de congelación.
Estas soluciones refrigerantes son buenos conductores, la transferencia de calor es rápida y la congelación se produce en poco tiempo.
Las sustancias que se utilizan como refrigerantes para este tipo de congelación deben ser no tóxicas, no aportar olor ni sabor desagradables al alimento, bajo poder de penetración en el alimento y no reaccionar con ningún componente del alimento.
Ejemplos: Salmueras (NaCl) se utilizan para congelar pescado; soluciones de sacarosa para congelar frutas; soluciones de NaCl y sacarosa, soluciones de CaCl2, glicerol, propilenglicol, nitrógeno líquido (no se utiliza por su elevado coste).
EFECTO DE LA CONGELACIÓN EN LOS MICROORGANISMOS
Según la noción clásica de microorganismos psicrófilos, éstos son organismos capaces de crecer a temperaturas desde por debajo de 0ºC hasta 20ºC, teniendo una temperatura óptima de 10-15ºC.
Actualmente en la microbiología alimentaria se acepta que un microorganismo psicrófilo es aquel capaz de crecer formando colonias visibles (turbidez) en temperaturas de 0 a 7ºC.
En un principio se pensó que estos microorganismos procedían de hábitats fríos y se encontraban únicamente en alimentos conservados en frío (0-7ºC), pero hoy en día se sabe que algunos de estos microorganismos son capaces de crecer también a temperaturas tan altas como 43ºC.
Actualmente se diferencia entre los microorganismos psicrófilos entre aquellos que crecen en un rango de temperaturas estrecho (estenopsicrotrofo) y un rango de temperaturas amplio (euripsicrotrofo), entre los últimos encontramos bacterias como Enterobacter cloacae, Listeria monocytogenes y Yersinia enterocolítica. Entre las estenopsicrótrofas se encuentra Aeromonas hydrophila.
La temperatura más baja de crecimiento registrada en un microorganismo de interés en los alimentos es de –34ºC, en este caso una levadura de color rosa.
El crecimiento a temperaturas por debajo de los 0ºC es más probable en el caso de levaduras y mohos, ya que éstas tienen requerimientos de aw más bajos.
Se conocen bacterias que crecen entre el intervalo –12 a –20ºC, los alimentos que mantienen crecimiento bacteriano a temperaturas bajo cero, incluyen concentrados de zumos de fruta y helados.
Es bien sabido que las temperaturas de congelación destruyen determinados microorganismos de importancia en los alimentos, los puntos destacados mediante los cuales se produce esta destrucción son los siguientes:
- Mortalidad súbita en el momento de la congelación (rotura de las envolturas celulares debido a la formación de cristales), que es variable según la especie.
- El porcentaje de las células que sobreviven inmediatamente después de la congelación del alimento muere poco a poco cuando éstos se conservan en estado congelado.
- La disminución del número de microorganismos es relativamente rápida a temperaturas inmediatamente inferiores a las del punto de congelación, especialmente alrededor de –2ºC, pero no es tan rápida a temperaturas más bajas, y generalmente es lenta por debajo de –20ºC.
De las bacterias causantes de intoxicaciones alimentarias, las salmonelas son menos resistentes que Staphylococcus aureus o que las células de los Clostridium, mientras que las esporas y las toxinas causantes de intoxicaciones alimentarias aparentemente no resultan afectadas por las temperaturas bajas.
En el caso de las salmonelas, se observó que tras el almacenamiento a temperaturas de congelación (-25,5ºC) a los 9 meses, se redujo la población de salmonelas viables de 1.67 ·107 a 3,4 · 106 Salmonella typhimurium/g.
EFECTO DE LA DESCONGELACIÓN EN LOS MICROORGANISMOS

La operación de descongelación tiene una gran importancia en la supervivencia de los microorganismos que han sido congelados. La congelación y descongelación sucesivas destruyen las bacterias debido a la rotura de las envolturas celulares.
Asimismo, cuanto más rápida es la descongelación, mayor es el número de bacterias supervivientes. Aunque no está comprobado, se cree que los microorganismos no mueren como consecuencia de la congelación, sino más bien durante la fase de descongelación.
Se sabe que como consecuencia de la descongelación se produce la condensación de agua en la superficie. También en la superficie hay una concentración general de sustancias hidrosolubles como, por ejemplo, aminoácidos, sales minerales, vitaminas y posiblemente otros nutrientes.
La congelación tiene el efecto de destruir muchos microorganismos termófilos y mesófilos, esto contribuye a que después de la descongelación exista menos competidores entre los microorganismos supervivientes.
Es comprensible que un mayor número de microorganismos psicrófilos en la superficie de los alimentos descongelados pueda alterarlos con mayor rapidez, algunos de los psicrófilos pueden doblar su tasa de crecimiento con sólo un aumento de temperatura de 4 a 5ºC (nevera), la rapidez y gravedad en la alteración del alimento descongelado depende de varios factores como el número y tipo de microorganismos presentes o el tipo de congelación.
Conservación por Frío: LISTERIOSIS (Listeria monocytogenes)

Listeria monocitogenes crece a 1ºC y su temperatura máxima de crecimiento es 45ºC, es una bacteria que se encuentra en vegetales en descomposición, tierra, heces de animales, aguas residuales, agua, se ha encontrado también en todo tipo de alimentos, pero se asocia especialmente a los productos lácteos.
Es imprescindible una correcta higiene y un tratamiento térmico adecuado para evitar su presencia en los alimentos.
Síndromes
El curso de la enfermedad depende del estado del hospedador. Las mujeres sanas que no están en estado de gestación son muy resistentes a la infección por Listeria monocitogenes.
Sin embargo, se sabe que hay estados que predisponen a padecer listeriosis, con importante porcentaje de mortalidad: neoplasia, SIDA, alcoholismo, diabetes (especialmente tipo I), enfermedades cardiovasculares, trasplante renal y la terapia con corticoesteroides.
Cuando las personas sensibles contraen la enfermedad, los síntomas más identificados son la sepsis y la meningitis. En las mujeres gestantes, el aborto, el parto prematuro o el nacimiento de un niño muerto es con frecuencia la consecuencia de la listeriosis.
Cuando el recién nacido se infecta en el momento del parto, los síntomas son meningitis, en algunos casos precedidos de vómitos, dolor abdominal y diarrea.
Conservación por Frío: YERSINIOSIS (Yersinia enterocolítica)

La Yersinia enterocolítica crece en un intervalo de temperaturas de –2 a 45ºC. Resiste bien la congelación (ej. ligero descenso de la población en carne de pollo después de 90 días a –18ºC, pero no resiste la pasteurización.
Están muy distribuidas en medio terrestre y en agua, pero está más adaptada al intestino de animales y personas. Se ha encontrado en todo tipo de alimentos, pero parece que la principal fuente son la carne de cerdo y la leche cruda, mal pasteurizada o recontaminada.
Síndrome por infección de Yersinia
Además de producir gastroenteritis (dolor abdominal y diarrea varios días después de la ingestión de alimentos contaminados), este microorganismo se ha relacionado, entre otros, con la pseudo-apendicitis, la ileítis terminal, la peritonitis y los abscesos de colon.
Tiene incidencia estacional, siendo más frecuente en octubre y noviembre, con incidencia máxima en personas muy jóvenes o ancianas.
Conservación por Frío: Aeromonas hydrophila
Las Aeromonas son bacterias acuáticas relacionadas con la diarrea, pero su papel en la etiología del síndrome gastrointestinal está poco claro. Se encuentra en aguas saladas más que en aguas dulces, es un patógeno importante para animales marinos y anfibios.
Es un patógeno también para el ser humano, especialmente en el caso de los hospedadores inmunocomprometidos. Aeromonas hydrophila provoca diarrea, endocarditis y meningitis.
La mayor parte de las cepas producen enterotoxina citotóxica (forma poros en las membranas de las células del hospedador).
Más de la mitad de sus cepas pueden crecer a temperaturas de 0 a 5ºC, su temperatura máxima de crecimiento es de 40 a 45ºC con una temperatura óptima de 15 a 20ºC, por lo que su incidencia es mayor durante el verano.
En un estudio en el que se evaluaron 147 hábitats acuáticos, únicamente en 12 no se encontró Aeromonas hydrophila. Se transmite por consumo de animales acuáticos y por consumo de aguas que contienen Aeromonas.
Descargo de responsabilidad
Hemos realizado todos los esfuerzos posibles para garantizar que la información proporcionada sea precisa, actualizada y completa, pero no se ofrece ninguna garantía al respecto.
Esta información es un recurso de referencia diseñado como un complemento y no un sustituto de la experiencia, habilidad, conocimiento de los profesionales de la salud, ni pretende ser un diagnóstico ni una terapia referenciada.
La ausencia de una advertencia para un determinado suplemento/alimento o la combinación de los mismos no debe interpretarse de ninguna manera como una indicación de seguridad, eficacia o idoneidad para un paciente determinado.
Ultimos artículos publicados
[insert page=»282907″ display=»content»]
Bibliografía y fotos:
- Repositorio de fotos de canva
- Apuntes personales de Microbiología